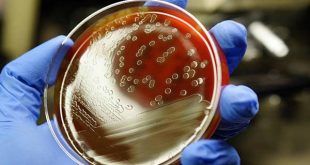

Este miércoles, la Secretaría de Salud ofreció una conferencia de prensa en torno al Nuevo Coronavirus, donde afirmaron que no hay razón para que los mexicanos entren en pánico por un posible brote en el país. Durante la charla, encabezada por el Doctor Hugo López-Gatell, subsecretario de Prevención y Promoción …
LEER MÁSUna higiene adecuada en manos ayuda a prevenir enfermedades respiratorias
La UMF No. 59 brinda aproximadamente 400 consultas por semana, por infecciones respiratorias, en ambos turnos En caso de presentar estornudos, flujo nasal, tos, fiebre y/o malestar en general, acuda a su Unidad de Medicina Familiar (UMF) para que se le otorgue tratamiento adecuado La temporada invernal continua y con …
LEER MÁSSepticemia: la terrible enfermedad que envenena la sangre y mata a más personas que el cáncer en el mundo
Una de cada cinco muertes en el mundo es causada por septicemia, también conocida como el “envenenamiento de la sangre”. Según un estudio de la Universidad de Washington basado en registros médicos de 195 naciones, 11 millones de personas mueren al año a causa de esta enfermedad, más de las …
LEER MÁS¿Cómo prevenir la sordera y detectar a tiempo la pérdida de audición?
La pérdida de audición discapacitante o sordera afecta a 466 millones de personas en el mundo de las cuales 34 millones son niños. Por pérdida de audición discapacitante se entiende una detrimento de audición superior a 40dB en el oído con mejor audición en los adultos, y superior a 30dB …
LEER MÁS¿Qué pueden comer y beber las mujeres embarazadas?
A lo largo de nueve meses, las mujeres embarazadas deben cuidar su alimentación para evitar enfermedades o el contagio de algún virus durante la etapa de gestación. La flexibilidad sobre qué alimentos y bebidas están permitidas o no, siempre y cuando el médico se los haya permitido es variable. Según …
LEER MÁSBajo observación un probable caso de coronavirus en México, señala AMLO
López Obrador detalló que en Tamaulipas puede haber un probable caso de coronavirus de Wuhan, el cual está bajo observación El presidente Andrés Manuel López Obrador detalló que en México hay dos casos de coronavirus, de los cuales uno ya fue descartado como coronavirus de Wuhan, que ya causó la …
LEER MÁSGarantiza López Obrador servicio a salud a los no asegurados
El presidente Andrés Manuel López Obrador inició este día la presentación del informe semanal “El Pulso de la Salud” que se hará los martes de cada semana y que originalmente se denominaría “Quién es quién en la salud”. Durante su conferencia matutina, indicó que se garantizará la atención médica a …
LEER MÁSAceite de soya podría causar autismo y Alzheimer, según estudio
El aceite de soya no sólo conduce a la obesidad y la diabetes, sino también podría ocasionar afecciones neurológicas como autismo, Alzheimer, ansiedad y depresión, de acuerdo con un estudio de la Universidad de California Riverside. El estudio, publicado en la revista Endocrinology, constó en comparar a ratones alimentados con …
LEER MÁSRemedios caseros agravan cuadro clínico de acné, dice especialista
De no ser indicados por un especialista, los remedios caseros o productos milagro disponibles en el mercado pueden agravar el cuadro clínico del acné de manera importante, aseguró el doctor Julio Enríquez Merino. Para tratar el acné se deben evitar los remedios caseros porque pueden ocasionar reacciones alérgicas (…). Entre …
LEER MÁSComer rápido aumenta 115% el riesgo de sobrepeso y obesidad
¿Eres consciente de cuánto tardas en comer? Pensemos un momento: ¿cuántos minutos le dedicamos a la comida o a la cena? ¿Somos de los que comemos demasiado deprisa o por el contrario le dedicamos un tiempo suficientemente amplio, masticamos bien los alimentos, sabiendo en todo momento cuánta comida estamos ingiriendo? …
LEER MÁS Yucatán al Instante Noticias al Instante
Yucatán al Instante Noticias al Instante